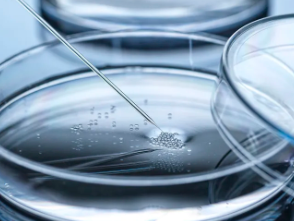
image.png

臍帶血干細(xì)胞存儲(chǔ)價(jià)值何在,其應(yīng)用前景又如何呢
2024-12-04 16:32:37 來源: 小編 咨詢醫(yī)生
臍帶血干細(xì)胞存儲(chǔ)近年來受到了越來越多的關(guān)注,作為一種寶貴的生物資源,它具有極高的醫(yī)學(xué)價(jià)值和廣泛的應(yīng)用前景。那么,臍帶血干細(xì)胞存儲(chǔ)的價(jià)值何在,其應(yīng)用前景又如何呢?
一、臍帶血干細(xì)胞存儲(chǔ)的價(jià)值
臍帶血中含有豐富的干細(xì)胞,這些干細(xì)胞具備分化成多種類型細(xì)胞的能力,因此在臨床治療中具有極高的應(yīng)用價(jià)值。臍帶血干細(xì)胞存儲(chǔ)的價(jià)值主要體現(xiàn)在以下幾個(gè)方面:
1.治療疾?。耗殠а杉?xì)胞可以用于治療多種疾病,如血液系統(tǒng)疾病、免疫系統(tǒng)疾病、神經(jīng)系統(tǒng)疾病等。其中,最常見的應(yīng)用是治療白血病、地中海貧血等血液病。
2.個(gè)體化治療:臍帶血干細(xì)胞來源于自身,避免了免疫排斥的風(fēng)險(xiǎn),因此在治療疾病時(shí)具有較高的安全性。同時(shí),個(gè)體化治療可以降低治療成本,提高治療效果。
3.資源豐富:臍帶血干細(xì)胞來源廣泛,每個(gè)新生兒出生時(shí)都可以收集到臍帶血。這意味著臍帶血干細(xì)胞資源豐富,可以為更多人提供治療機(jī)會(huì)。
4.儲(chǔ)存時(shí)間長(zhǎng):臍帶血干細(xì)胞在合適的條件下可以長(zhǎng)期儲(chǔ)存,為患者提供長(zhǎng)期的治療保障。
二、臍帶血干細(xì)胞應(yīng)用前景
1.個(gè)性化醫(yī)療:隨著生物技術(shù)的發(fā)展,臍帶血干細(xì)胞在個(gè)性化醫(yī)療領(lǐng)域的應(yīng)用前景廣闊。通過對(duì)臍帶血干細(xì)胞的基因編輯,可以實(shí)現(xiàn)對(duì)疾病的治療和預(yù)防。
2.組織工程:臍帶血干細(xì)胞可以用于組織工程,如心臟、肝臟、神經(jīng)等組織的修復(fù)和再生。這將極大地提高器官移植的成功率,減輕患者痛苦。
3.藥物研發(fā):臍帶血干細(xì)胞可以作為藥物篩選的平臺(tái),為新藥研發(fā)提供有力支持。通過觀察干細(xì)胞在不同藥物作用下的生長(zhǎng)、分化情況,可以篩選出具有潛在治療效果的藥物。
4.基礎(chǔ)研究:臍帶血干細(xì)胞為研究人員提供了研究人類發(fā)育、分化、疾病發(fā)生等過程的寶貴資源。通過對(duì)臍帶血干細(xì)胞的研究,有望揭示生命奧秘,為醫(yī)學(xué)發(fā)展奠定基礎(chǔ)。
三、總結(jié)
臍帶血干細(xì)胞存儲(chǔ)具有極高的價(jià)值,不僅為臨床治療提供了豐富的資源,還為未來醫(yī)學(xué)發(fā)展奠定了基礎(chǔ)。隨著科技的進(jìn)步,臍帶血干細(xì)胞的應(yīng)用前景將更加廣闊,為人類健康帶來更多福祉。因此,我們應(yīng)當(dāng)重視臍帶血干細(xì)胞的存儲(chǔ)和應(yīng)用,讓這一寶貴的生命資源發(fā)揮最大的價(jià)值。
- 2024-10-16干細(xì)胞存儲(chǔ)費(fèi)用,干細(xì)胞存儲(chǔ)的意義是什么
- 2024-12-02干細(xì)胞存儲(chǔ)的意義與價(jià)值體現(xiàn)在哪些方面
- 2024-10-24造血干細(xì)胞存儲(chǔ)費(fèi)用是多少?存儲(chǔ)流程詳解。
- 2024-11-27廣州干細(xì)胞存儲(chǔ)機(jī)構(gòu)有哪些,選擇標(biāo)準(zhǔn)是什么
- 2024-10-25合肥人體干細(xì)胞存儲(chǔ)哪家可靠?存儲(chǔ)費(fèi)用如何?
- 2024-09-13臍帶血造血干細(xì)胞存儲(chǔ)有意義嗎,能治療哪些疾病
- 2024-08-27自體干細(xì)胞移植痛苦嗎,自體干細(xì)胞移植步驟過程介紹
- 2024-08-05蘋果干細(xì)胞長(zhǎng)期吃的副作用,蘋果干細(xì)胞多少錢一支
- 2024-09-12蘋果干細(xì)胞價(jià)格是多少,一盒能用多久
- 2024-10-04干細(xì)胞療法見效快慢有別?多久才能看到明顯效果?
- 2024-09-04博雅干細(xì)胞存儲(chǔ)多少錢一年,博雅干細(xì)胞收費(fèi)標(biāo)準(zhǔn)
- 2024-09-02多能干細(xì)胞的作用和功效有哪些
- 2024-08-07干細(xì)胞生發(fā)技術(shù),干細(xì)胞生發(fā)技術(shù)成熟嗎
- 2024-10-11江蘇干細(xì)胞培養(yǎng)費(fèi)用如何??jī)r(jià)格與效果成正比嗎?
- 2024-07-30干細(xì)胞抗衰老費(fèi)用,干細(xì)胞抗衰老是真的嗎
- 2024-10-03造血干細(xì)胞匹配幾率,怎樣增加匹配可能性
- 2024-09-12怎樣選擇干細(xì)胞儲(chǔ)存機(jī)構(gòu),這五點(diǎn)至關(guān)重要
- 2024-10-09臉部松弛打干細(xì)胞效果真的好嗎,如何選擇靠譜的干細(xì)胞機(jī)構(gòu)
